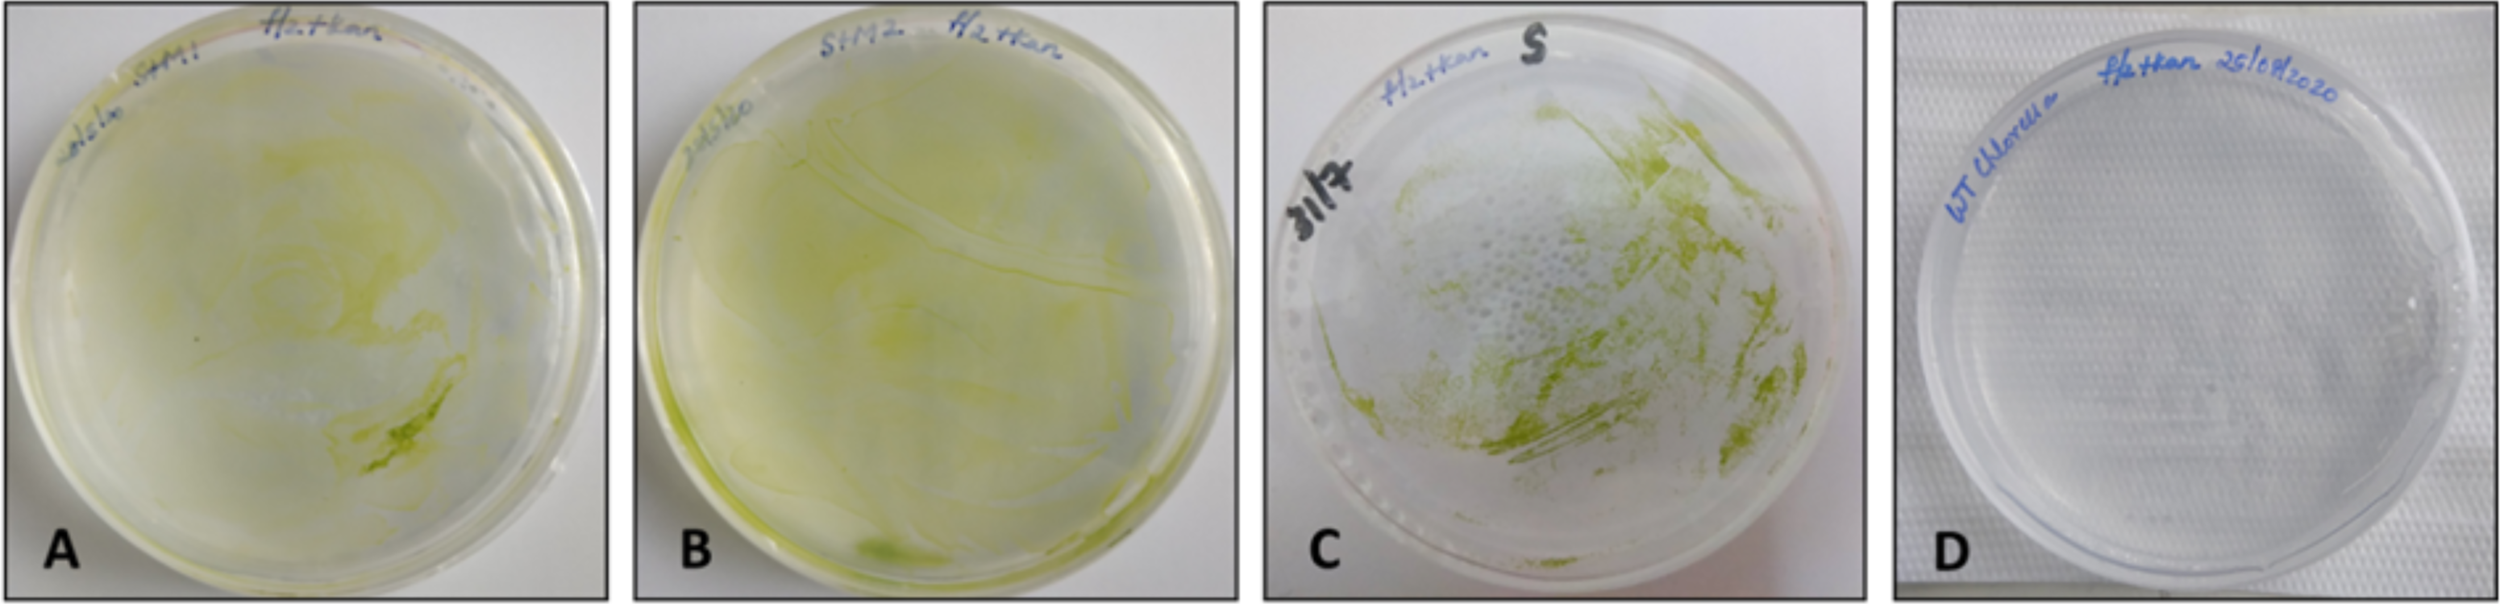
Figure 2

Abstract
Microalgae constitute a diverse group of photosynthetic unicellular microorganisms that have gained immense attention for biotechnological applications. They are promising platforms for the production of high-value metabolites and biopharmaceuticals for commercial and therapeutic applications because of their physiological properties and capability to grow easily in natural and artificial environments. Although the proof-of-concept for some applications have been achieved for model species, such as Chlamydomonas reinhardtii, the genetic engineering methods for microalgae are still in their infancy. Thus, an expansion of this field is required. Chlorella vulgaris is an important algal species with a high protein content and requires focus for the development of an efficient nuclear and chloroplast transformation process. This research aimed to establish a chloroplast transformation method for the freshwater green-algae species C. vulgaris based on a specific expression vector (pCMCC, which was named after Chula Mexico Chlorella chloroplast) constructed with endogenous recombination regions, namely, 16S–trn I (left) and trn A–23S (right), and the Prrn promoter. Human basic fibroblast growth factor (bFGF) was adopted as a target biopharmaceutical to establish the chloroplast expression approach. The plasmid pCMCC:bFGF was transformed into C. vulgaris via electroporation using simple carbohydrate-based buffers, which aided in the transfer of the transgene into the chloroplast genome. Cells transformed with the pCMCC:bFGF vector were selected using kanamycin, and resistant colonies were analyzed by polymerase chain reaction and Western blotting to confirm the presence of the transgene and the recombinant bFGF, respectively. The bFGF that accumulated in the transplastomic C. vulgaris clones ranged from 0.26 to 1.42 ng/g fresh weight of biomass, and it was quantified by enzyme-linked immunosorbent assay. Therefore, the designed expression vector, in combination with an optimized electroporation protocol, constitutes a viable approach to successfully develop transplastomic lines of C. vulgaris for the potential low-cost production of biopharmaceuticals using this algal species. This study paves the way for the establishment of chloroplast biotechnology in microalgae other than the model organism C. reinhardtii.
Introduction
The global population is on exponential rise with the drastic depletion of naturally available products, leading to a high requirement of valuable biologicals. Thus, an expansion of such productive systems is required to meet their demand. Hence, the current scenario redirects to the development of alternative strategies for the production of such molecules in high yields using safe and economical technologies (Siddiqui et al., 2020). With the advent of genetic engineering, various platforms, such as those based on bacteria (Huang et al., 2012; Gupta and Shukla, 2016; Demain and Vaishnav, 2009), yeast (Ahmad et al., 2014; Kim et al., 2015; Baghban et al., 2019; Huertas and Michán, 2019), mammalian cells (Hacker and Balasubramanian, 2016; Gupta et al., 2017; Owczarek et al., 2019; O'Flaherty et al., 2020), insect cells (Contreras-Gómez et al., 2014; Felberbaum, 2015; Kost and Kemp, 2016), plants (Shanmugaraj and Ramalingam, 2014; Lomonossoff and D'Aoust, 2016; Shanmugaraj et al., 2020), and transgenic animals (Moura et al., 2011; Maksimenko et al., 2013), have been largely and profoundly studied to explore the potential to develop them as mature platforms for the heterologous expression of proteins that have commercial and industrial importance (Merlin et al., 2014). However, although advances in the use of expression hosts for sustainable bioprocesses for the production of high-value products have been achieved, many challenges still need to be overcome in this field. Such challenges include strategies such as diminishing the risk of contamination (Mycoplasma, bacterial, viral, fungal, and endotoxin) (Merten, 2002; Stacey, 2011; Singh et al., 2020), meeting the regulatory requirements, reduction in operational costs, improving the process controls, and robustness in the environmental conditions and testing methods (Tripathi and Shrivastava, 2019; Kumar et al., 2020).
Eukaryotic unicellular microalgae comprise a vast diversified group of organisms that have been adopted as a promising platform for the production of recombinant products with a wide set of applications (Hallmann, 2015). The distinctive features of microalgae, such as habitat, nutrient requirements, and behavioral patterns, make these organisms an attractive platform for biotechnological applications. Apart from having great ecological and economical importance, microalgae are being utilized in the food, feed, fertilizer, cosmetic, and pharmaceutical industries because they are natural bio-factories enriched with valuable molecules, such as proteins, pigments, polysaccharides, lipids, and nutraceuticals (Lordan et al., 2011; Milledge, 2011; Ibañez et al., 2012; Yaakob et al., 2014; Nur and Buma, 2019). Therefore, these ubiquitous (Metting, 1996) and heterogeneous groups of microalgae are promising platforms for the production of a wide range of biological compounds. These microorganisms need to be genetically modified using advanced molecular tools to exploit their full potential for beneficial purposes.
Microalgae are simpler yet more complex organisms for gene manipulation in comparison with higher plants due to the absence of cell differentiation. Although significant efforts have been exerted to establish molecular tools and techniques for the genetic manipulation of microalgae (Potvin and Zhang, 2010; Ashwini et al., 2016; Tanwar et al., 2018; Kumar et al., 2020; Mutanda et al., 2020), they remain a fairly unexplored area to overcome the difficulty in the efficient delivery of exogenous DNA within the cytoplasm, nucleus, or chloroplast in microalgae given that they are single-cell entities with a thick cell wall (Ortiz-Matamoros et al., 2018; Fajardo et al., 2020). The most commonly used techniques to introduce foreign DNA into microalgal cells are cell bombardment with DNA-coated gold or tungsten particles (Sizova et al., 1996; El-Sheekh, 2000; Remacle et al., 2006; Xie et al., 2014; Li et al., 2016; Yuan et al., 2019) and glass bead agitation (Economou et al., 2014; Adachi et al., 2017), followed by Agrobacterium tumefaciens-mediated transformation (Kumar et al., 2004; Pratheesh et al., 2014) and electroporation (Ladygin, 2003; Kumar et al., 2004; Herz et al., 2005; Zhang et al., 2014; Kang et al., 2015; Gan et al., 2018). Other methods used include the agitation with foreign plasmid DNA and silicon carbide whiskers (Dunahay, 1993) and polyethylene glycol (PEG) (Maliga, 2004). However, gene manipulation in algae is not easily attained, unlike in bacterial or plant cells, posing various scientific hassles due to the multifarious cell sizes, complex and multitudinous cell wall components, and confining transformation methods to a limited number of species (Doron et al., 2016; Ortiz-Matamoros et al., 2018; Gan et al., 2018).
The Chlorella genus represents one of the specialized groups of green algae that can produce high levels of proteins with rapid growth rate and large cell densities in controlled conditions, thereby drawing attention toward the genetic manipulation of their genomes (Yang et al., 2016). The Chlorella species possess a robust cell wall with a protective function, acting as a strong barrier to extract high-value compounds enclosed in the cell and limiting the insertion process of exogenous DNA. In particular, the Chlorella vulgaris cell wall is composed of a single microfibrillar layer at the beginning of the growth phase, followed by the development of a two-layer structure, where the thick outer and thin inner layers constitute the mother and daughter cell walls, respectively. The cell wall of C. vulgaris consists of 20–25% neutral sugars, 10–20% uronic acids, 7–17% glucosamine, 6–10% proteins, monosaccharides, such as rhamnose (20 to 34%), arabinose (12 to 20%), and glucose (16 to 46%), and a rigid fraction of polysaccharides, including chitin or chitosan. The cell wall increases from 82 ± 20 nm in the exponential phase to 114 ± 24 nm in the stationary phase, whereby the nascent cell wall is usually thin and fragile, and the thickness gradually increases in the developed phase (Takeda, 1988; Kapaun and Reisser, 1995; Canelli et al., 2021; Weber et al., 2022). These cell wall characteristics are a major hurdle and should be addressed during the development of a novel genetic transformation approach.
Although the majority of genetically modified organisms are generated by the integration of transgenes in their genome, the case of photosynthetic organisms also offers the opportunity for adopting chloroplast transformation. Such organelles are remnants of endosymbiotic cyanobacteria that have gained great interest for genetic manipulation due to their homologous recombination system, facilitating the site-specific integration of foreign DNA, which avoids position effects and leads to a high copy number for the transgene; however, no silencing processes have been found in these organelles (Daniell et al., 2002; Vafaee et al., 2014). Strong specific promoters [cauliflower mosaic virus 35S (CaMV35S) promoter, α-tubulin, RBCS2, PSAD, Prrn, FCP, NIT1, and Ubi1-Ω] may lead to a higher transgene expression level with protein accumulations (Metting, 1996; Mayfield et al., 2003; Mayfield et al., 2007; Potvin and Zhang, 2010; Rasala et al., 2011; Hallmann, 2015; Doron et al., 2016; Hamed, 2016; Adem et al., 2017; Zhang et al., 2017; Baier et al., 2018; Mutanda et al., 2020). Apart from regulatory elements, the ribosome binding site (RBS) plays a pivotal role in protein translation (Specht and Mayfield, 2013). Therefore, compared with nuclear genome manipulation, the transformation of the chloroplast genome offers various advantages, namely, uniform transgene expression and compartmentalization of the produced recombinant proteins in the chloroplast without affecting other cellular processes (Georgianna and Mayfield, 2012; Doron et al., 2016; Siddiqui et al., 2020). Achievements in chloroplast transformation have been reported in higher plants, such as tobacco, lettuce, rapeseed, potato, tomato, petunia, soybean, and cotton, and some monocots, including rice; cotton, as an efficient system for the expression of functional recombinant proteins, uses specific plastid promoter-driven and other genetic factors (Daniell et al., 2002; Verma and Daniell, 2007; Wani et al., 2015; Daniell et al., 2021). The research and development of plastid microalgal biotechnology are still a major obstacle given that such technology is well established only for the model species Chlamydomonas reinhardtii (Bateman and Purton, 2000; Mayfield et al., 2007; Rasala and Mayfield, 2011; Rosales-Mendoza et al., 2012; Almaraz-Delgado et al., 2014; Economou et al., 2014; Munjal et al., 2014; Scranton et al., 2015; Larrea-Alvareza and Purton, 2020). Other species engineered at the chloroplast genome level include Platymonas subcordiformis (Cui et al., 2014; Siddiqui et al., 2020), Nannochloropsis oceanica (Gan et al., 2018; Siddiqui et al., 2020), Phaeodactylum tricornatum (Xie et al., 2014; Serif et al., 2018), Dunaliella tertiolecta (Georgianna et al., 2013; Anila et al., 2016), and Haematococcus pluvialis (Gutiérrez et al., 2012; Wang et al., 2020).
Chlorella is a genus of considerable interest in biotechnology because its species are extensively applied for commercial use as a food supplement due to their high biomass, nutritive value, and ability to grow easily in mixotrophic conditions (Spolaore et al., 2006; Kent et al., 2015; Cecchin et al., 2019). For C. vulgaris, anti-colorectal cancer activity and immunomodulatory effects associated to exopolysaccharides and long-term diet have been described, respectively (Cheng et al., 2017; Zhang et al., 2019). In addition, C. vulgaris can be used in medical treatments for non-communicable diseases, such as hypertension, cataract, and dyslipidemia (Panahi et al., 2016; Xie et al., 2018). On the other hand, the development of genetic engineering strategies for their emergent use as bioreactors for the production of recombinant proteins and biopharmaceuticals has attracted scientific interest. In a previous work, protoplasts obtained from C. vulgaris C-27 were used for nuclear transformation via the PEG method, and a subsequent heterologous expression of human growth hormone (hGH) was achieved. Moreover, the strategy encompassed the addition of an extracellular signal sequence for hGH secretion into the extracellular medium, the use of geneticin as an antibiotic for selection, and the assay of CaMV35s and rbcS2 promoters. The hGH was expressed in the range of 200–600 ng/ml (Hawkins and Nakamura, 1999). Wang et al. (2021) reported a chloroplast transformation-based system in which two codon-optimized antimicrobial peptides (NZ2114 and piscidin-4) were co-expressed; the green microalga C. vulgaris was transformed via microparticle bombardment, and the homoplastic transformants were screened using spectinomycin as a selectable marker.
Hence, to target the semi-autonomous replicating chloroplast organelle for genetic engineering in C. vulgaris, this study focused on the assembly of a species-specific DNA vector to produce high-value proteins. A specific plastid expression vector, namely, pCMCC (named after Chula Mexico Chlorella chloroplast), was designed to express various recombinant genes in C. vulgaris. The human basic fibroblast growth factor (bFGF) was selected as a representative biopharmaceutical to be expressed using the pCMCC vector. This protein has a significant commercial demand. As an example, the bFGF may be indicated in diverse disciplines of dentistry, such as dental traumatology and periodontics, due to its capability to induce the differentiation and proliferation of cells. Thus, it is a useful tool for the development of natural structures. The production process for this protein can be rapidly scaled up using a transplastomic microalgal strain formerly modified with a simple and efficient transformation method. In the current study, the potential of the pCMCC vector applying the electroporation method for chloroplast transformation of C. vulgaris was assessed, and a rapid approach of the method using carbohydrate-based buffers was accomplished.
Materials and Methods
Microalgal Growth Conditions
An axenic culture of C. vulgaris was obtained from the Thailand Institute of Scientific and Technological Research, Pathum Thani, Thailand. The C. vulgaris culture was grown in f/2 media without silicates or Bold’s basal medium (BBM) from Phyto Tech Labs. The C. vulgaris cultures were incubated on a rotary shaker (150 rpm) for 1 week at 28 ± 1°C with cool fluorescent lamps at a photosynthetic photon flux density of 80–100 µmol m−2 s−1 and a 16:8-h light/dark cycle. Thereafter, a routine subculture was performed by transferring the cultures to a fresh culture medium every 7 days. For chloroplast transformation, C. vulgaris was inoculated at 20% (v/v) in fresh f/2 media and cultivated for 4 to 5 days at 150 rpm until the growth approached the log phase. The cell count was performed by using a hemocytometer, and the cell number was adjusted to 5 × 106 cells/ml with f/2 media and grown for 24–48 h before competent cell preparation for chloroplast transformation.
Vector Construction and Transformation into Escherichia coli
A species-specific plastid transformation vector called pCMCC was constructed to test the integration and expression of the human bFGF gene (the amino acid sequence was obtained from GenBank with accession number: AAQ73204.1) through homologous recombination in the C. vulgaris plastid genome. The homologous recombination elements were designed as R1 (16S-trnI) and R2 (trnA-23S), where the R1 and R2 regions comprise 2171 and 2000 nt, respectively. The expression cassette was led by the Prrn promoter (Klein et al., 1992) from C. reinhardtii, untranslated region (UTR) from T7 phage (Herz et al., 2005), Aph6 selection marker gene (Bateman and Purton, 2000) flanked by psbA terminator (Eibl et al., 1999), and bFGF gene optimized for expression in C. vulgaris linked with 8X histidine tag. The bFGF gene was flanked by XhoI and SacI restriction sites to further facilitate the replacement with other genes of interest. The expression cassette possessed a bicistronic arrangement that allowed the expression of the bFGF gene and marker Aph6, which conferred kanamycin resistance to the transformed cells under the control of the Prrn promoter. An RBS (Koop et al., 1996) sequence was placed between the open reading frames to mediate the translation of the second gene (Aph6) in the bicistronic arrangement. Figure 1 shows the schematic representation of pCMCC:bFGF vector. The bFGF gene was subjected to a codon optimization protocol before synthesis, which allowed the achievement of a codon adaptation index of 0.96 with a GC content of 43.8%, which maximized RNA stability and its translation rate. The recombination flanks and expression cassette were fully synthesized by GenScript (New Jersey, USA) and confirmed by sequencing. The pCMCC vector is under patenting process (DIP TH Petition No. 2001006378). The expression vector was transformed into Escherichia coli TOP10 cells by heat shock, and the resulting clones were confirmed by polymerase chain reaction (PCR). The pCMCC:bFGF plasmid was isolated from the confirmed E. coli clones using a Presto™ mini plasmid kit (Geneaid, Taiwan) and further confirmed by PCR and restriction profiling.
Figure 1

Diagrammatic representation of the pCMCC:bFGF vector. R1, recombination region comprising 16S rRNA gene and TrnI genes from Chlorella vulgaris genome (NC_ 001865.1); Prrn, promoter region from Prrn gene from Chlamydomonas reinhardtii; SwaI, restriction enzyme site; T7 5′ UTR, 5′ untranslated region from gene 10 of T7 phage; XhoI/XbaI, restriction sites for the cloning gene of interest; bFGF, encodes the human bFGF along with His-tag at the N-terminus end; SacI, restriction site for cloning the gene of interest; Aph6, selectable marker gene conferring resistance to kanamycin; BamHI, restriction enzyme site; 3′ psb A, UTR at the 3′ end from psbA gene; R2, recombination region from the C. vulgaris genome (NC_ 001865.1) comprises the genes for TrnA, ORF64, ORF41a, and ORF74 and a part of the 23S rRNA gene. The amplified sequences using specific primers are marked with arrows.
Chloroplast Transformation in C. vulgaris by Electroporation
Two methods were employed for the chloroplast transformation in C. vulgaris using pulse field electroporation. The first methodology was based on the procedure reported by Ji and Fan (2020). The microalgal cells were centrifuged, and the pellet was washed in ice-cold hypertonic buffer solution containing 0.2 M mannitol and 0.2 M sorbitol for 1 h by immersion in ice. The algal cells were centrifuged and resuspended in 1 ml electroporation buffer (0.2 M mannitol, 0.2 M sorbitol, 0.08 M KCl, 0.005 M CaCl2, and 0.01 M HEPES; pH 7.2). The cell density was adjusted to 5 × 106 cells ml−1. Then, 30 µg/ml circular and linearized pCMCC:bFGF DNA and 50 µg salmon sperm DNA were added to 100 µl cell suspension in an electric-shock cuvette and kept in an ice bath for 5 min. Electroporation was carried out using a Bio-Rad Gene-Pulser X cell apparatus at a pulse voltage of 643 V and width of 2.3 ms. Later, the cells were recovered after incubation with ice for 10 min, added with 200 µl BBM, and incubated at 30°C for 1 h. The algal cells were collected by centrifugation at 4°C for 2 min at 16,000 rpm, and the pellet was resuspended in 10 ml BBM and kept in the dark overnight at 25°C with continuous agitation. After recovery, the cells were plated on BBM agar plates containing kanamycin (50 mg/L).
Another method employed was based on the use of a sorbitol buffer for chloroplast transformation with modifications as described in the work of Li et al. (2020). C. vulgaris was inoculated into fresh f/2 medium to achieve a final cell concentration of 2 × 106 cells in the culture media; the cells were cultivated as per the growth conditions mentioned in the section “Microalgal Growth Conditions”. After 4 to 5 days of growth, 200 ml of Chlorella cells at the early log phase was harvested by centrifugation at 4,000 rpm for 10 min at 4°C. The harvested cells were washed with ice-cold 6.8% sorbitol for 6 to 7 times. The cells were resuspended in ice-cold sorbitol to attain a final cell count of 2 × 107 cells/ml. Then, 3 µg pCMCC:bFGF DNA and linearized and non-linearized denatured salmon sperm DNA (30–50 µg) were added to 0.2 ml cells. The control was also kept with algal cells and salmon sperm DNA only. The algal cells and plasmid DNA were thoroughly mixed and transferred to a 2-mm cuvette and incubated in ice for 10 min prior to electroporation. Electroporation was carried out with parameters of 2,200 V and 3.5 ms. After electroporation, the cells were transferred to f/2 liquid medium and incubated at 25–28°C with minimal agitation. Following the 24-h dark incubation, the cells were recovered and plated on f/2 agar plates supplemented with 50 mg/L kanamycin. The plates were incubated at room temperature under continuous light intensity until the appearance of independent colonies. Emerging independent colonies with uniform phenotypes from both methods were further grown in media with 20 mg/L antibiotic for four rounds of selection and screened for molecular confirmation.
DNA Isolation and Confirmation by PCR
The independently transformed colonies were selected from the BBM and f/2 selection agar plates and inoculated in fresh f/2 liquid media supplemented with kanamycin. After 5 to 6 days of culture, 50 ml of each culture was centrifuged at 5,000 rpm for 5 min. The supernatant was discarded, and the total biomass was resuspended in the extraction buffer [100 mM Tris-HCl, pH 8.0, 50 mM ethylenediaminetetraacetic acid (pH 8.0), 500 mM NaCl, and 2% cetrimonium bromide]. Then, 1 ml glass beads (acid washed, 425–600 µm; Sigma, St. Louis, MO, USA) was added to the suspensions, and cell disruption was performed in a Mixer Mill MM400 (Retsch®). After grinding, the cell debris were removed by centrifugation at 12,000 rpm for 10 min, and the supernatants were subjected to phenol/chloroform/isoamyl alcohol (25:24:1, v/v) (Sigma, St. Louis, MO, USA) treatment for DNA purification.
PCR was performed in 20-µl reaction mixtures containing Phusion GC Buffer (1X), deoxynucleoside triphosphate (1 mM), Phusion DNA Polymerase (0.02 U/µl), dimethyl sulfoxide (3%), DNA template (50–100 ng), and 0.5 µM of each primer (forward: 5′GCAACTACTTTCCGTTTAGC3′, reverse: 5′CGAGCTCTCAAAGCTCATCCTTTTCAGAAGACTTGGCGCTCATAGG3′) to amplify the sequence comprising the bFGF gene and R1 region (2.8 kb) (Figure 1). The temperature cycling conditions were 98°C for 2 min (initial denaturation), 30 cycles at 98°C for 30 s (denaturation), 60°C for 30 s (annealing), 72°C for 1.25 min (elongation), and a final extension at 72°C for 10 min. The negative control consisted of the DNA from an untransformed C. vulgaris. This procedure was performed in a Bio-Rad Thermal Cycler. The PCR products were analyzed on 1.5% agarose gel electrophoresis.
Protein Extraction
Chloroplast-transformed algal cultures that were confirmed by PCR were grown in liquid f/2 with kanamycin at 20 mg/L and collected for protein extraction. A total of 50 mg fresh biomass was homogenized in 100 µl extraction buffer containing 750 mM Tris-HCl at pH 8.0 with 15% sucrose, 100 mM β-mercaptoethanol, and 1 mM phenylmethylsulfonyl fluoride as described previously (Bañuelos-Hernández et al., 2017). The extracts were sonicated for 4 pulses for 10 s with an interval of 5 s in between (Malla et al., 2021). The samples were subsequently centrifuged at 8000 rpm for 15 min, and the supernatants were collected for further analysis. The total soluble proteins (TSPs) in the extracts were determined by the Bradford method.
Sodium Dodecyl Sulfate Polyacrylamide Gel Electrophoresis
SDS-PAGE was performed in a Mini-Protean® Electrophoresis System from Bio-Rad under reducing–denaturing conditions. Stacking and separating gels were prepared using 4 and 12% acrylamide, respectively. TSPs (5–10 µg, approximately 50 µl) were mixed with 4X reducing loading buffer, denatured by boiling for 10 min at 95°C, and subsequently loaded onto a stacking gel. Electrophoresis was carried out at 100 V for 2 h and monitored using the molecular weight marker “Precision Plus Protein ™ Dual Color Standards” (Bio-Rad, Vienna, Austria). The gels were stained with Coomassie® Brilliant Blue R-250 (Bio-Rad, Vienna, Austria) at a final formulation of 0.05% (w/v) dye, 10% acetic acid, 50% (v/v) methanol, and 40% distilled water.
Western Blot Analysis
Recombinant protein expression was analyzed by Western blotting. TSPs (5–10 µg, approximately 50 µl) were mixed with 4X reducing loading buffer, denatured by boiling for 10 min at 95°C, and subsequently subjected to SDS-PAGE analysis. The gels were blotted onto 0.45 µm nitrocellulose membranes. Protein transfer was performed using a Bio-Rad electroblotter for 1 h at 100 V in a methanol-based transfer buffer. The nitrocellulose blot was further processed for immunodetection. After blocking with 5% skimmed milk dissolved in 1X phosphate-buffered saline (PBS) for 1 h, the blots were incubated at 4°C overnight with a rabbit anti-His antibody tagged with horseradish peroxidase conjugate (ab1187, Abcam, UK) at 1:5,000 dilution in 3% fat-free milk dissolved in 1X PBS. The blot was washed thrice with PBS containing 0.05% Tween 20. Protein detection was revealed by incubating the blots with SuperSignal West Pico Plus Chemiluminescent Substrate solution, following the manufacturer’s instructions (Thermo Scientific, http://www.thermoscientific.com), and exposing the film in the dark.
Quantification by Enzyme-Linked Immunosorbent Assay
The bFGF that accumulated in the transplastomic lines of C. vulgaris was quantified using the human FGF basic ELISA Kit (R&D System, Minneapolis, USA). The protocol was performed in accordance with the manufacturer’s instructions. All the reagents provided in the kit were brought to room temperature before performing the assay. A total of 100 µl assay diluent was obtained in each microwell, to which 100 µl standard and sample extracts was added and incubated at room temperature for 2 h. The extracts were subjected to twofold dilution in PBS (pH 7.2) and used as samples for ELISA quantification. The plates were washed with a wash buffer, and 200 µl human FGF basic conjugate was added to each well. After 2 h of incubation, the plate was washed, and 200 µl substrate was added, followed by 30 min of incubation in the dark. The reaction was stopped by the addition of the stop solution, and the optical density was measured at 450 nm. For the quantification studies, three biological replicates were obtained, and each sample was subjected to two technical replicates.
Results
To obtain a C. vulgaris chloroplast expression vector, we adopted a fully synthetic approach and molecular cloning techniques to lay the recombination regions along with the expression cassette coding for the selective marker and the gene of interest, allowing the assembly of the pCMCC:bFGF vector in a pUC background; the physical map is shown in Figure 1. The pCMCC was designed to mediate the integration of an expression cassette for the bFGF gene through the homologous recombination into C. vulgaris chloroplasts. The optimized bFGF, which was inserted into the XhoI at the 5′ end and the SacI site at the 3′ end, was under the control of the Prrn promoter from C. reinhardtii and the psbA terminator. The Aph6 gene, which confers kanamycin resistance, was located in a bicistronic arrangement and led by the same transcriptional elements.
The green microalga C. vulgaris was grown for 5–7 days in f/2 media without silicates and further used for chloroplast transformation by electroporation using sorbitol–mannitol and sorbitol buffers. Transformed emergent colonies appeared on f/2 agar selection plates after 2 to 3 weeks in both buffer methods, and the wild-type Chlorella cells showed no growth in the selective medium. Isolated colonies from sorbitol–mannitol with nonlinearized pCMCC:bFGF plasmid (SM-NL), sorbitol–mannitol with linearized pCMCC:bFGF plasmid (SM-L), and sorbitol with linearized pCMCC:bFGF plasmid (S–L) plates (colonies 1 and 2) were picked and inoculated in f/2 liquid media without silicates and containing 20 mg/L kanamycin to confirm the kanamycin-resistant phenotype of the putative transformed algal cultures. No transformed colonies were observed in the case of sorbitol buffer with nonlinearized plasmid. The grown transformed cultures were further subcultured in the routine f/2 antibiotic media for 4 rounds at 6- to 8-day intervals for molecular screening (Figure 2). After four rounds of selection, the clones were screened by PCR using the R1 region/bFGF-specific primer set, which led to the detection of a 2.8-kb PCR product in the samples from the kanamycin-resistant clones obtained by electroporation using sorbitol–mannitol and sorbitol buffers; DNA from the wild-type C. vulgaris was used as the negative control. The expected amplicon was observed in the chloroplast-transformed colonies using both buffer methods. Figure 3 shows the absence of amplification in the wild type.
Figure 2
Chloroplast-transformed Chlorella vulgaris cells by electroporation with sorbitol–mannitol and sorbitol buffers plated on f/2 agar plates with 50 mg/L kanamycin. (A) SM-L transformed cells, (B) SM-NL transformed cells, (C) S-L transformed cells in colony 1, and (D) wild-type C. vulgaris cells on antibiotic selection plate.
Figure 3

PCR confirmation of chloroplast-transformed Chlorella vulgaris with pCMCC:bFGF. M, DNA ladder; WT, wild-type C. vulgaris DNA; lane 1, SM-L colony; lane 2, SM-NL colony; lane 3, S-L colony 1; lane 4, S-L colony 2; lane 5, negative reaction control. The 2.8-kb amplicon is indicated by an arrow.
The fresh biomass collected from chloroplast-transformed cultures of C. vulgaris with bFGF was lysed and used for protein extraction. The total proteins were visualized on SDS-PAGE gel with Coomassie blue staining (Figure 4A). The expression of the recombinant bFGF in transplastomic C. vulgaris clones was further evaluated by Western blot analyses. The bFGF protein was observed at the expected molecular weight of approximately 25 kDa in the Western blot for colonies obtained using the sorbitol–mannitol and sorbitol methods (Figure 4B). The wild-type extract did not show any immunoreactive band, validating the specificity of the assay (Figure 4B, lane 5). Hence, these results confirmed that the constructed pCMCC vector can be used for the chloroplast transformation of C. vulgaris via electroporation.
Figure 4

(A) SDS-PAGE pattern of the total soluble protein obtained from the transformed and wild-type Chlorella vulgaris. Gel stained with Coomassie brilliant blue. M, molecular weight marker; line 1, SM-L colony; lane 2, SM-NL colony; lane 3, S-L colony 1; lane 4, S-L colony 2; WT, wild type (negative control). (B) Western blot analysis of bFGF protein produced in the chloroplast of C. vulgaris. Crude proteins were extracted from chloroplast-transformed C. vulgaris cultures, and the expression of bFGF protein was analyzed on SDS-PAGE, followed by Western blot, and probed with a rabbit anti-his antibody conjugated with HRP. M, molecular weight marker; lane 1, SM-L colony; lane 2, SM-NL colony; lane 3, S-L colony 1; lane 4, S-L colony 2; WT, wild type (negative control). The 25-kDa band corresponding to the bFGF protein is indicated by an arrow.
The bFGF yields in the transplastomic clones were determined by sandwich ELISA using a commercial kit. The bFGF protein yields were 0.26, 0.27, 1.42, and 0.56 ng/g in the SM-L colony, SM-NL colony, S-L colony 1, and S-L colony 2, respectively (Figure 5). Although the bFGF expression was low, it accounted for 0.005–0.4% of TSPs in the tested transplastomic clones, thereby confirming the functional activity of the expression vector in the chloroplast of C. vulgaris. However, the expressed recombinant bFGF protein in the chloroplast genome needs to be further explored using various promoters and regulatory elements to achieve higher protein yields. The purification procedures and functional analysis of the expressed bFGF shall be further studied.
Figure 5

The expression levels of bFGF in chloroplast-transformed Chlorella vulgaris cultures were measured by ELISA. C. vulgaris was transformed with pCMCC:bFGF plasmid using sorbitol–mannitol and sorbitol buffers by electroporation. Line 1, SM-L colony; lane 2, SM-NL colony; lane 3, S-L colony 1; lane 4, S-L colony 2; control, C. vulgaris + sperm DNA. The result was presented on the fresh weight basis. The data are expressed as mean ± standard deviation of three biological replicates with each sample (1:1 dilution) obtained in independent duplicates.
Discussion
Given the limited studies on the chloroplast transformation of green algae other than the model species C. reinhardtii, the present research focused on generating a species-specific vector targeting the chloroplast genome of C. vulgaris and assessing its functionality via electroporation-mediated transformation to achieve the expression of bFGF. The first step in the development of chloroplast transformation methods comprises the construction of species-specific chloroplast expression vector, which requires many PCR-based amplifications of flanking regions intended to mediate the homologous recombination with the target genome and multiple cloning steps to assemble the expression cassette. A fully synthetic approach was followed as a straightforward way to assemble the C. vulgaris-specific vector (pCMCC), which comprised flanking sequences and a bicistronic expression cassette that mediates the transcription of the Aph6 and bFGF genes. The species-specific chloroplast flanking sequences trnI/trnA were elected to mediate the site-directed insertion of the expression cassette in a manner that avoids the interruption of endogenous genes. Moreover, the trnI gene contains a chloroplast replication origin which mediates vector replication and thus may promote its integration into the target genome (Quesada-Vargas et al., 2005). The other feature of the pCMCC vector is the use of long sequences mediating the homologous recombination with the target genome, where the left side contains partial 16S rRNA and full-length trnI and the right targeting region contains trnA and partial 23S rRNA (Quesada-Vargas et al., 2005; Verma et al., 2008; Chen et al., 2020).
The expression cassette carried in the pCMCC vector comprises the Prrn promoter (Klein et al., 1992) from C. reinhardtii, the 3′ UTR from T7 phage (Herz et al., 2005), and the Aph6 selection marker gene (Bateman and Purton, 2000) flanked by psbA terminator (Eibl et al., 1999). The 5′/3′ regulatory sequences were aimed at augmenting the capability of transcription and translation of the foreign gene. Plastid gene expression is regulated at the transcriptional and post-transcriptional levels. Therefore, the protein expression levels depend on the strength of the promoter, mRNA concentration, and its stability, but at a higher extension of translation efficiency (Verma and Daniell, 2007). Hence, in the present study, in addition to selecting a strong promoter, efficient UTRs and codon optimization were adopted to promote the efficient translation of transcripts and ultimately favor the recombinant protein accumulation. Five different restriction sites were included along with these elements to facilitate the further modifications of the vector or the replacement of the gene of interest (Figure 1).
In this work, the plasmid pCMCC was transformed into C. vulgaris cells in sugar alcohol buffers by electroporation, and the resultant transformants were selected on a kanamycin-containing medium. Meanwhile, untransformed cells were unable to grow on the selective medium. Certain microalgal cells have the potential to carry episomal plasmids (Xie et al., 2014). Hence, the transformed C. vulgaris cells were examined and confirmed by PCR and Western blotting (Figures 3, 4, respectively). The expressed bFGF was further quantified by ELISA to confirm the FGF expression levels in the transformed lines (Figure 5). The sorbitol and sorbitol–mannitol buffer-based transformation resulted in transformed clones. Although the transformation efficiency was not calculated, the linearization of the plasmid affected the number of colonies that appeared on the selection medium. The nonlinearized plasmid that was used in the transformation methods with sorbitol–mannitol showed very few colonies, whereas sorbitol did not show any transformed clones. The amount of bFGF protein expression quantified by ELISA was higher in the case of sorbitol-linearized plasmid-transformed colonies compared with that in the case of sorbitol–mannitol-linearized plasmid. This study is the first report on plastid genetic transformation based on an electroporation gene delivery using sorbitol in C. vulgaris without employing cumbersome, time-consuming, and tedious procedures. To date, most plastid transformations rely on the biolistic approach, which is an expensive process with periodical maintenance limiting its use (Xie et al., 2014). In C. vulgaris, a previous work on chloroplast genetic engineering has been reported, with the authors co-expressing two antimicrobial peptides via microparticle bombardment using gold particles. The transformant screening employing spectinomycin as a resistance marker was accomplished; subsequent DNA integration and transgene expression by PCR, Southern blotting, and Western blotting were achieved (Wang et al., 2021).
The present research formed a basis to extend the use of sorbitol–mannitol buffers for the electroporation method of other microalgal species at a lower cost and a feasible manner for chloroplast engineering. Although the heterologous gene expression in the chloroplast of C. vulgaris has been achieved with relatively low expression levels in terms of percent of TSP, the obtained yields in the present study are higher in comparison with those of other reports on nuclear C. reinhardtii expression, such as the nucleocapsid antigen from hepatitis B virus fused with angiotensin II (0.05% TSP), p24 human immunodeficiency virus antigen (0.25% of the total cellular protein), and human epidermal growth factor (0.25% TSP) (Soria-Guerra et al., 2014; Barahimipour et al., 2016; Baier et al., 2018). In addition, the bFGF levels expressed in C. vulgaris chloroplast genome surpassed the yields of some proteins produced in C. reinhardtii chloroplast, such as bacterial endoglucanase (CelK1, glycohydrolase, family 5) (0.003% TSP), the major birch pollen allergen, Bet v 1 (0.01–0.04% TSP), human glutamic acid decarboxylase 65 (0.25–0.3% TSP), and VapA antigens from the fish bacterial pathogen Aeromonas salmonicida (0.3% TSP) (Wang et al., 2008; Michelet et al., 2011; Faè et al., 2017; Hirschl et al., 2017). However, the low expression levels obtained in our study despite the use of a transplastomic approach can be attributed to a mechanism involved at multiple levels, such as transcription, mRNA processing, mRNA stability, and translation of the recombinant gene. Improvements in the expression vector design using different promoter sequences or regulatory elements should be considered.
On the other hand, the electroporation process requires different parameters that can be modified to optimize a protocol for a specific microalgal species. The main adjustments encompass the voltage, resistance, capacitance, pulse duration, temperature, number of pulses, culture medium composition, growth capability, addition of carrier DNA, concentration of exogenous DNA, and solid medium for maximal cloning efficiency (Coll, 2006). In this sense, future investigations focusing on parameter modification will be performed to optimize the electroporation-based chloroplast transformation process.
Genetic modifications are generally performed on the nuclear genome of host organisms. In the last decades, chloroplasts have become attractive hosts, gaining huge interest due to the following advantages with respect to nuclear transformation: high expression levels associated to the high copy number reached for the transgene and low or no position effect due to exogenous DNA integration in particular sites by homologous recombination (Jin and Daniell, 2015; Zhang et al., 2017; Tanwar et al., 2018; Chen et al., 2020; Daniell et al., 2021). Over the past few years, plastid transformation technology has been successfully applied in higher plants to express foreign proteins to achieve agronomic traits or has led to platforms for the production of enzymes, metabolites, and pharmaceuticals (Wani et al., 2015; Jin and Daniell, 2015; Ahmad et al., 2016. Bock, 2015). The chloroplast transformation in model alga C. reinhardtii is well established and used routinely for the expression of various heterologous proteins. C. vulgaris is another green algal species that has a high nutritive value with economically important characteristics but lacks an efficient stable and transformation method due to its thick cell wall. In this study, the fully synthetic approach adopted for straightforward construction provided a useful model that may allow the redesign of the vector for optimization purposes and expand the transformation of other algal species using a simple and robust transformation method.
Conclusion
The pCMCC plasmid constructed using the promoter region Prrn from C. reinhardtii was successfully applied to transfer the bFGF gene into the plastome of C. vulgaris via electroporation using sorbitol and mannitol-based buffers, leading to the expression of the target recombinant protein. To the best of our knowledge, this research is the first study to show evidence on the capacity of electroporation-mediated transformation method using a specific chloroplast vector obtained by a fully synthetic approach in the development of transplastomic technologies for C. vulgaris, which is a small and rigid alga. The obtained pCMCC vector will be the basis for the design of next-generation vectors to ultimately optimize the expressions of foreign proteins in the chloroplast of C. vulgaris. This study represents a starting point of plastid engineering for green algal species by simple electroporation method where the transformation frequency and expression levels remain to be improved. A routine procedure with insertion of more sites for recombination, selectable markers, and strong promoters in streamline with the specific electroporation conditions should be undertaken for engineering of the plastids, which are recalcitrant by biolistic particle bombardment or PEG-mediated transformation methods in relevant microalgal species. The effort to expand the plastid algal biotechnology will lead to mature platforms for the production of metabolites and recombinant protein expression and holds a great promise for commercialization in nutritional, therapeutic, and industrial applications, making these host systems a competitive production platform.
Funding
The present work was financially supported by the Rachadapisek Sompote Fund for Innovation (no. CU_GI_62_08_33_01).
Publisher’s Note
All claims expressed in this article are solely those of the authors and do not necessarily represent those of their affiliated organizations, or those of the publisher, the editors and the reviewers. Any product that may be evaluated in this article, or claim that may be made by its manufacturer, is not guaranteed or endorsed by the publisher.
Statements
Data availability statement
The original contributions presented in the study are included in the article/supplementary material. Further inquiries can be directed to the corresponding authors.
Author contributions
SV and SR-M conceived, designed, and supervised the study. SV obtained the funding for this work. SR-M wrote, reviewed, and edited the manuscript. AM performed the experiments, analyzed the data, designed the figures, and wrote the original draft. OCB-M performed the experiments, analyzed the data, designed the figures, and wrote, reviewed, and edited the manuscript. All authors contributed to the article and approved the submitted version.
Acknowledgments
OB-M is a recipient of the Second Century Fund (C2F), Chulalongkorn University, and thank for the financial support during this research.
Conflict of interest
The authors declare that the research was conducted in the absence of any commercial or financial relationships that could be construed as a potential conflict of interest.
Supplementary material
The Supplementary Material for this article can be found online at: https://www.frontiersin.org/articles/10.3389/fmars.2022.884897/full#supplementary-material
References
1
Adachi T. Sahara T. Okuyama H. Morita N. (2017). Glass Bead-Based Genetic Transformation: An Efficient Method for Transformation of Thraustochytrid Microorganisms. J. Oleo Sci.66, 791–795. doi: 10.5650/jos.ess17084
2
Adem M. Beyene D. Feyissa T. (2017). Recent Achievements Obtained by Chloroplast Transformation. Plant Methods13, 30. doi: 10.1186/s13007-017-0179-1
3
Ahmad M. Hirz M. Pichler H. Schwab H. (2014). Protein Expression in Pichia Pastoris: Recent Achievements and Perspectives for Heterologous Protein Production. Appl. Microbiol. Biotechnol.98, 5301–5317. doi: 10.1007/s00253-014-5732-5
4
Ahmad N. Michoux F. Lössl A. G. Nixon P. J. (2016). Challenges and Perspectives in Commercializing Plastid Transformation Technology. J. Exp. Bot.67, 5945–5960. doi: 10.1093/jxb/erw360
5
Almaraz-Delgado A. L. Flores-Uribe J. Pérez-España V. H. Salgado-Manjarrez E. Badillo-Corona J. A. (2014). Production of Therapeutic Proteins in the Chloroplast of Chlamydomonas Reinhardtii. AMB Express4, 57. doi: 10.1186/s13568-014-0057-4
6
Anila N. Simon D. P. Chandrashekar A. Ravishankar G. A. Sarada R. (2016). Metabolic Engineering of Dunaliella Salina for Production of Ketocarotenoids. Photosynth. Res.127, 321–333. doi: 10.1007/s11120-015-0188-8
7
Ashwini M. Murugan S. B. Balamurugan S. Sathishkumar R. (2016). Advances in Molecular Cloning. Mol Biol. 50, 1–6. doi: 10.1134/S0026893316010131
8
Baghban R. Farajnia S. Rajabibazl M. Ghasemi Y. Mafi A. Hoseinpoor R. et al . (2019). Yeast Expression Systems: Overview and Recent Advances. Mol. Biotechnol.61, 365–384. doi: 10.1007/s12033-019-00164-8
9
Baier T. Kros D. Feiner R. C. Lauersen K. J. Müller K. M. Kruse O. (2018). Engineered Fusion Proteins for Efficient Protein Secretion and Purification of a Human Growth Gactor From the Green Microalga Chlamydomonas Reinhardtii. ACS Synth Biol.16, 2547–2557. doi: 10.1021/acssynbio.8b00226
10
Baier T. Wichmann J. Kruse O. Lauersen K. J. (2018). Intron-Containing Algal Transgenes Mediate Efficient Recombinant Gene Expression in the Green Microalgae Chlamydomonas Reinhardtii. Nucleic Acids Res.46, 6909–6919. doi: 10.1093/nar/gky532
11
Bañuelos-Hernández B. Monreal-Escalante E. González-Ortega O. Angulo C. Rosales-Mendoza S. (2017). Algevir: An Expression System for Microalgae Based on Viral Vectors. Front. Microbiol.8. doi: 10.3389/fmicb.2017.01100
12
Barahimipour R. Neupert J. Bock R. (2016). Efficient Expression of Nuclear Transgenes in the Green Alga Chlamydomonas: Synthesis of an HIV Antigen and Development of a New Selectable Marker. Plant Mol. Biol.90, 403–418. doi: 10.1007/s11103-015-0425-8
13
Bateman J. M. Purton S. (2000). Tools for Chloroplast Transformation in Chlamydomonas: Expression Vectors and a New Dominant Selectable Marker. Mol. Gen. Genet.263, 404–410. doi: 10.1007/s004380051184
14
Bock R. (2015). Engineering Plastid Genomes: Methods, Tools, and Applications in Basic Research and Biotechnology. Annu. Rev. Plant Biol.66, 211–241. doi: 10.1146/annurev-arplant-050213-040212
15
Canelli G. Murciano Martínez P. Austin S. Ambühl M. E. Dionisi F. Bolten C. J. et al . (2021). Biochemical and Morphological Characterization of Heterotrophic Crypthecodinium Cohnii and Chlorella Vulgaris Cell Walls. J. Agric. Food Chem.69, 2226–2235. doi: 10.1021/acs.jafc.0c05032
16
Cecchin M. Marcolungo L. Rossato M. Girolomoni L. Cosentino E. Cuine S. et al . (2019). Chlorella Vulgaris Genome Assembly and Annotation Reveals the Molecular Basis for Metabolic Acclimation to High Light Conditions. Plant J.100, 1289–1305. doi: 10.1111/tpj.14508
17
Cheng D. Wan Z. Zhang X. Li J. Li H. Wang C. (2017). Dietary Chlorella Vulgaris Ameliorates Altered Immunomodulatoru Functions in Cyclophosphamide-Induced Immunosupressive Mice. Nutrients.9, 708. doi: 10.3390/nu9070708
18
Coll J. M. (2006). Methodologies for Transferring DNA Into Eukaryotic Microalgae: a Review. Spanish J. Agric. Res.4:316–330.
19
Contreras-Gómez A. Sánchez-Mirón A. García-Camacho F. Molina-Grima E. Chisti Y. (2014). Protein Production Using the Baculovirus-Insect Cell Expression System. Biotechnol. Prog.30, 1–18. doi: 10.1002/btpr.1842
20
Cui Y. Qin S. Jiang P. (2014). Chloroplast Transformation of Platymonas (Tetraselmis) Subcordiformis With the Bar Gene as Selectable Marker. PLoS One9, e98607. doi: 10.1371/journal.pone.0098607
21
Daniell H. Jin S. Zhu X. G. Gitzendanner M. A. Soltis D. E. Soltis P. S. (2021). Green Giant-a Tiny Chloroplast Genome With Mighty Power to Produce High-Value Proteins: History and Phylogeny. Plant Biotechnol. J.19, 430–447. doi: 10.1111/pbi.13556
22
Daniell H. Khan M. S. Allison L. (2002). Milestones in Chloroplast Genetic Engineering: An Environmentally Friendly Era in Biotechnology. Trends Plants Sci.7, 84–91. doi: 10.1016/s1360-1385(01)02193-8
23
Demain A. L. Vaishnav P. (2009). Production of Recombinant Proteins by Microbes and Higher Organisms. Biotechnol. Adv.27, 297–306. doi: 10.1016/j.biotechadv.2009.01.008
24
Doron L. Segal N. Shapira M. (2016). Transgene Expression in Microalgae-From Tools to Applications. Front. Plant Sci.7. doi: 10.3389/fpls.2016.00505
25
Dunahay T. G. (1993). Transformation of Chlamydomonas Reinhardtii With Silicon Carbide Whiskers. Bio. Techniques15, 452–460.
26
Economou C. Wannathong T. Szaub J. Purton S. (2014). A Simple, Low-Cost Method for Chloroplast Transformation of the Green Alga Chlamydomonas Reinhardtii. Methods Mol. Biol.1132, 401–411. doi: 10.1007/978-1-62703-995-6_27
27
Eibl C. Zou Z. Beck A. Kim M. Mullet J. et al . (1999). In Vivo Analysis of Plastid Psba, rbcL and Rpl32 UTR Elements by Chloroplast Transformation: Tobacco Plastid Gene Expression is Controlled by Modulation of Transcript Levels and Translation Efficiency. Plant J.19, 333–345. doi: 10.1046/j.1365-313x.1999.00543.x
28
El-Sheekh M. M. (2000). Stable Chloroplast Transformation in Chlamydomonas Reinhardtii Using Microprojectile Bombardment. Folia Microbiol.45, 496–504. doi: 10.1007/BF02818717
29
Faè M. Accossato S. Cella R. Fontana F. Goldschmidt-Clermont M. Leelavathi S. et al . (2017). Comparison of Transplastomic Chlamydomonas Reinhardtii and Nicotiana Tabacum Expression System for the Production of a Bacterial Endoglucanase. Appl. Microbiol. Biotechnol.101, 4085–4092. doi: 10.1007/s00253-017-8164-1
30
Fajardo C. De Donato M. Carrasco R. Martínez-Rodríguez G. Mancera J. M. Fernández-Acero F. J. (2020). Advances and Challenges in Genetic Engineering of Microalgae. Rev. Aquac.12, 365–381. doi: 10.1111/raq.12322
31
Felberbaum R. S. (2015). The Baculovirus Expression Vector System: A Commercial Manufacturing Platform for Viral Vaccines and Gene Therapy Vectors. Biotechnol. J.10, 702–714. doi: 10.1002/biot.201400438
32
Gan Q. Jiang J. Han X. Wang S. Lu Y. (2018). Engineering the Chloroplast Genome of Oleaginous Marine Microalga Nannochloropsis Oceanica. Front. Plant Sci.9. doi: 10.3389/fpls.2018.00439
33
Georgianna D. R. Hannon M. J. Marcuschi M. Wu S. Botsch K. Lewis A. J. et al . (2013). Production of Recombinant Enzymes in the Marine Alga Dunaliella Tertilolecta. Algal Res.2, 2–9. doi: 10.1016/j.algal.2012.10.004
34
Georgianna D. R. Mayfield S. P. (2012). Exploiting Diversity and Synthetic Biology for the Production of Algal Biofuels. Nature.488, 329–335. doi: 10.1038/nature11479
35
Gupta S. K. Shukla P. (2016). Advanced Technologies for Improved Expression of Recombinant Proteins in Bacteria: Perspectives and Applications. Crit. Rev. Biotechnol.36, 1089–1098. doi: 10.3109/07388551.2015.1084264
36
Gupta S. K. Srivastava S. K. Sharma A. Nalage V. Salvi D. Kushwaha H. et al . (2017). Metabolic Engineering of CHO Cells for the Development of a Robust Protein Production Platform. PLoS One12, e0181455. doi: 10.1371/journal.pone.0181455
37
Gutiérrez C. L. Gimpel J. Escobar C. Marshall S. H. Henríquez V. (2012). Chloroplast Genetic Tool for the Green Microalgae Haematococcus Pluvialis (Chlorophyceae, Volvocales) (1). J. Phycol.48, 976–983. doi: 10.1111/j.1529-8817.2012.01178.x
38
Hacker D. L. Balasubramanian S. (2016). Recombinant Protein Production From Stable Mammalian Cell Lines and Pools. Curr. Op. Struct. Biol.38, 129–136. doi: 10.1016/j.sbi.2016.06.005
39
Hallmann A. (2015). Algae Biotechnology – Green Cell-Factories on the Rise. Curr. Biotech.04, 389–415. doi: 10.2174/2211550105666151107001338
40
Hamed I. (2016). The Evolution and Versatility of Microalgal Biotechnology: A Review. Compr. Rev. Food Sci. Food Saf.15, 1104–1123. doi: 10.1111/1541-4337.12227
41
Hawkins R. L. Nakamura M. (1999). Expression of Human Growth Hormone by the Eukaryotic Alga, Chlorella. Curr. Microbiol.38, 335–341. doi: 10.1007/pl00006813
42
Herz S. Füssl M. Steiger S. Koop H. U. (2005). Development of Novel Types of Plastid Transformation Vectors and Evaluation of Factors Controlling Expression. Transgenic Res.14, 969–982. doi: 10.1007/s11248-005-2542-7
43
Hirschl S. Ralser C. Asam C. Gangitano A. Huber S. Ebner C. et al . (2017). Expression and Characterization of Functional Recombinant Bet V 1.0101 in the Chloroplast of Chlamydomonas Reinhardtii. Int. Arch. Allergy Immunol.173, 44–50. doi: 10.1159/000471852
44
Huang C. J. Lin H. Yang X. (2012). Industrial Production of Recombinant Therapeutics in Escherichia Coli and its Recent Advancements. J. Ind. Microbiol. Biotechnol.39, 383–399. doi: 10.1007/s10295-011-1082-9
45
Huertas M. J. Michán C. (2019). Paving the Way for the Production of Secretory Proteins by Yeast Cell Factories. Microb. Biotechnol.12, 1095–1096. doi: 10.1111/1751-7915.13342
46
Ibañez E. Herrero M. Mendiola J. A. Castro-Puyana M. (2012). “Extraction and Characterization of Bioactive Compounds With Health Benefits From Marine Resources: Macro and Micro Algae, Cyanobacteria, and Invertebrates,” in Marine Bioactive Compounds. Ed. HayesM. (Boston, MA: Springer), 55–98. doi: 10.1007/978-1-4614-1247-2_2
47
Ji L. Fan J. (2020). Electroporation Procedures for Genetic Modification of Green Algae (Chlorella Spp.). Methods Mol. Biol.2050, 181–185. doi: 10.1007/978-1-4939-9740-4_20
48
Jin S. Daniell H. (2015). The Engineered Chloroplast Genome Just Got Smarter. Trends Plant Sci.20, 622–640. doi: 10.1016/j.tplants.2015.07.004
49
Kang S. Kim K. H. Kim Y. C. (2015). A Novel Electroporation System for Efficient Molecular Delivery Into Chlamydomonas Reinhardtii With a 3-Dimensional Microelectrode. Sci. Rep.5, 15835. doi: 10.1038/srep15835
50
Kapaun E. Reisser V. (1995). A Chitin-Like Glycan in the Cell Wall of a Chlorella Sp. (Chlorococcales, Chlorophyceae). Planta.197, 577–582. doi: 10.1007/BF00191563
51
Kent M. Welladsen H. M. Mangott A. Li Y. (2015). Nutritional Evaluation of Australian Microalgae as Potential Human Health Supplements. PLoS One10, e0118985. doi: 10.1371/journal.pone.0118985
52
Kim H. Yoo S. J. Kang H. A. (2015). Yeast Synthetic Biology for the Production of Recombinant Therapeutic Proteins. FEMS yeast Res.15, 1–16. doi: 10.1111/1567-1364.12195
53
Klein U. De Camp J. D. Bogorad L. (1992). Two Types of Chloroplast Gene Promoters in Chlamydomonas Reinhardtii. Proc. Natl. Acad. Sci. United States America.89 (8), 3453–3457. doi: 10.1073/pnas.89.8.3453
54
Koop H. U. Steinmüller K. Wagner H. Rössler C. Eibl C. Sacher L. (1996). Integration of Foreign Sequences Into the Tobacco Plastome via Polyethylene Glycol-Mediated Protoplast Transformation. Planta199, 193–201. doi: 10.1007/BF00196559
55
Kost T. A. Kemp C. W. (2016). “Fundamentals of Baculovirus Expression and Applications,” in Advanced Technologies for Protein Complex Production and Characterization. Ed. VegaM. C. (Cham: Springer International Publishing), 187–197.
56
Kumar S. V. Misquitta R. W. Reddy V. S. Rao B. J. Rajam V. M. (2004). Genetic Transformation of the Green Alga-Chlamydomonas Reinhardtii by Agrobacterium Tumefaciens. Plant Sci.166, 731–738. doi: 10.1016/j.plantsci.2003.11.012
57
Kumar G. Shekh A. Jakhu S. Sharma Y. Kapoor R. Sharma T. R. (2020). Bioengineering of Microalgae: Recent Advances, Perspectives, and Regulatory Challenges for Industrial Application. Front. Bioeng. Biotechnol.8. doi: 10.3389/fbioe.2020.00914
58
Ladygin V. G. (2003). The Transformation of the Unicellular Alga Chlamydomonas Reinhardtii by Electroporation. Microbiology.72, 585–591. doi: 10.1023/A:1026051402366
59
Larrea-Alvareza M. Purton S. (2020). Multigenic Engineering of the Chloroplast Genome in the Green Alga Chlamydomonas Reinhardtii. Microbiol. (Reading England).166, 510–515. doi: 10.1099/mic.0.000910
60
Li D. W. Balamurugan S. Zheng J. W. Yang W. D. Liu J. S. Li H. Y. (2020). Rapid and Effective Electroporation Protocol for Nannochloropsis Oceanica. Methods Plant Biol.2050, 175–179. doi: 10.1007/978-1-4939-9740-4_19
61
Li X. Zhang R. Patena W. Gang S. S. Blum S. R. Ivanova N. et al . (2016). An Indexed, Mapped Mutant Library Enables Reverse Genetics Studies of Biological Processes in Chlamydomonas Reinhardtii. Plant Cell.28, 367–387. doi: 10.1105/tpc.15.00465
62
Lomonossoff G. P. D'Aoust M. A. (2016). Plant-Produced Biopharmaceuticals: A Case of Technical Developments Driving Clinical Deployment. Science (New York N.Y.)353, 1237–1240. doi: 10.1126/science.aaf6638
63
Lordan S. Ross R. P. Stanton C. (2011). Marine Bioactives as Functional Food Ingredients: Potential to Reduce the Incidence of Chronic Diseases. Mar. Drugs9, 1056–1100. doi: 10.3390/md9061056
64
Maksimenko O. G. Deykin A. V. Khodarovich Y. M. Georgiev P. G. (2013). Use of Transgenic Animals in Biotechnology: Prospects and Problems. Acta naturae.5, 33–46. doi: 10.32607/20758251-2013-5-1-33-46
65
Maliga P. (2004). Plastid Transformation in Higher Plants. Annu. Rev. Plant Biol.55, 289–313. doi: 10.1146/annurev.arplant.55.031903.141633
66
Malla A. Rosales-Mendoza S. Phoolcharoen W. Vimolmangkang S. (2021). Efficient Transient Expression of Recombinant Proteins Using DNA Viral Vectors in Freshwater Microalgal Species. Front. Plant Sci.12. doi: 10.3389/fpls.2021.650820
67
Mayfield S. P. Franklin S. E. Lerner R. A. (2003). Expression and Assembly of a Fully Active Antibody in Algae. Proc. Natl. Acad. Sci.100, 438–442. doi: 10.1073/pnas.0237108100
68
Mayfield S. P. Manuell A. L. Chen S. Wu J. Tran M. Siefker D. et al . (2007). Chlamydomonas Reinhardtii Chloroplasts as Protein Factories. Curr. Opin. Biotechnol.18, 126–133. doi: 10.1016/j.copbio.2007.02.001
69
Mayfield S. P. Manuelle A. L. Chen S. Wu J. Tran M. Siefker D. et al . (2007). Chlamydomonas Reinhardtii Chloroplasts as Protein Factories. Curr. Opin. Biotechnol.18, 126–133. doi: 10.1016/j.copbio.2007.02.001
70
Merlin M. Gecchele E. Capaldi S. Pezzotti M. Avesani L. (2014). Comparative Evaluation of Recombinant Protein Production in Different Biofactories: The Green Perspective. Biomed. Res. Int.2014, 136419. doi: 10.1155/2014/136419
71
Merten O. W. (2002). Virus Contaminations of Cell Cultures- A Biotechnological View. Cytotechnology.39, 91–116. doi: 10.1023/A:1022969101804
72
Metting F. B. (1996). Biodiversity and Applications of Microalgae. J. Ind. Microbiol.17, 477–489. doi: 10.1007/BF01574779
73
Michelet L. Lefebvre-Legendre L. Burr S. E. Rochaix J. D. Goldschmidt-Clermont M. (2011). Enhanced Chloroplast Transgene Expression in a Nuclear Mutant of Chlamydomonas. Plant Biotechnol. J.9, 565–574. doi: 10.1111/j.1467-7652.2010.00564.x
74
Milledge J. J. (2011). Commercial Application of Microalgae Other Than as Biofuels: A Brief Review. Rev. Environ. Sci. Biotechnol.10, 31–41. doi: 10.1007/s11157-010-9214-7
75
Moura R. R. Melo L. M. Freitas V. J. (2011). Production of Recombinant Proteins in Milk of Transgenic and non-Transgenic Goats. Braz. Arch. Biol. Technol.54, 927–938. doi: 10.1590/S1516-89132011000500010
76
Munjal N. Garzon-Sanabria A. J. Quinones K. Gregory J. Nikolov Z. L. (2014). Light-Induced Production of an Antibody Fragment and Malaria Vaccine Antigen From Chlamydomonas Reinhardtii. Processes.2, 625–638. doi: 10.3390/pr2030625
77
Mutanda T. Naidoo D. Bwapwa J. K. Anandraj A. (2020). Biotechnological Applications of Microalgal Oleaginous Compounds: Current Trends on Microalgal Bioprocessing of Products. Frontier Energy Res.8. doi: 10.3389/fenrg.2020.598803
78
Nur M. M. A. Buma A. G. J. (2019). Opportunities and Challenges of Microalgal Cultivation on Wastewater, With Special Focus on Palm Oil Mill Effluent and the Production of High Value Compounds. Waste Biomass Valor.10, 2079–2097. doi: 10.1007/s12649-018-0256-3
79
O'Flaherty R. Bergin A. Flampouri E. Mota L. M. Obaidi I. Quigley A. et al . (2020). Mammalian Cell Culture for Production of Recombinant Proteins: A Review of the Critical Steps in Their Biomanufacturing. Biotechnol. Adv.43, 107552. doi: 10.1016/j.biotechadv.2020.107552
80
Ortiz-Matamoros M. F. Villanueva M. A. Islas-Flores T. (2018). Genetic Transformation of Cell-Walled Plant and Algae Cells: Delivering DNA Through the Cell Wall. Brief. Funct. Genomics17, 26–33. doi: 10.1093/bfgp/elx014
81
Owczarek B. Gerszberg A. Hnatuszko-Konka K. (2019). A Brief Reminder of Systems of Production and Chromatography-Based Recovery of Recombinant Protein Biopharmaceuticals. BioMed. Res. Int.2019, 4216060. doi: 10.1155/2019/4216060
82
Panahi Y. Darvishi B. Jowzi N. Beiraghdar F. Sahebkar A. (2016). Chlorella Vulgaris: A Multifunctional Dietary Supplement With Diverse Medicinal Properties. Curr. Pharm. Des.22, 164–173. doi: 10.2174/1381612822666151112145226
83
Potvin G. Zhang Z. (2010). Strategies for High-Level Recombinant Protein Expression in Transgenic Microalgae: A Review. Biotechnol. Adv.28, 910–918. doi: 10.1016/j.biotechadv.2010.08.006
84
Chen P. Y. Tsai Y. T. To K. Y. (2020). Construction and Evaluation of Chloroplast Expression Vectors in Higher Plants. In Genetic Transformation in Crops. IntechOpen. doi: 10.5772/intechopen.91887
85
Pratheesh P. T. Vineetha M. Kurup G. M. (2014). An Efficient Protocol for the Agrobacterium-Mediated Genetic Transformation of Microalga Chlamydomonas Reinhardtii. Mol. Biotechnol.56, 507–515. doi: 10.1007/s12033-013-9720-2
86
Quesada-Vargas T. Ruiz O. N. Daniell H. (2005). Characterization of Heterologous Multigene Operons in Transgenic Chloroplasts: Transcription, Processing, and Translation. Plant Phys.138, 1746–1762. doi: 10.1104/pp.105.063040
87
Rasala B. A. Mayfield S. P. (2011). The Microalga Chlamydomonas Reinhardtii as a Platform for the Production of Human Protein Therapeutics. Bioengineered bugs.2, 50–54. doi: 10.4161/bbug.2.1.13423
88
Rasala B. A. Muto M. Sullivan J. Mayfield S. P. (2011). Improved Heterologous Protein Expression in the Chloroplast of Chlamydomonas Reinhardtii Through Promoter and 5´Untranslated Region Optimization. Plant Biotechnol. J.9, 674–683. doi: 10.1111/j.1467-7652.2011.00620.x
89
Remacle C. Cardol P. Coosemans N. Gaisne M. Bonnefoy N. (2006). High-Efficiency Biolistic Transformation of Chlamydomonas Mitochondria can be Used to Insert Mutations in Complex I Genes. Proc. Natl. Acad. Sci. United States America.103, 4771–4776. doi: 10.1073/pnas.0509501103
90
Rosales-Mendoza S. Paz-Maldonado L. M. Soria-Guerra R. E. (2012). Chlamydomonas Reinhardtii as a Viable Platform for the Production of Recombinant Proteins: Current Status and Perspectives. Plant Cell Rep.31, 479–494. doi: 10.1007/s00299-011-1186-8
91
Scranton M. A. Ostrand J. T. Fields F. J. Mayfield S. P. (2015). Chlamydomonas as a Model for Biofuels and Bio-Products Production. Plant J. Cell Mol. Biol.82, 523–531. doi: 10.1111/tpj.12780
92
Serif M. Dubois G. Finoux A. L. Teste M. A. Jallet D. Daboussi F. (2018). One-Step Generation of Multiple Gene Knock-Outs in the Diatom Phaeodactylum Tricornutum by DNA-Free Genome Editing. Nat. Commun.9:3924 doi: 10.1038/s41467-018-06378-9
93
Shanmugaraj B. M. Ramalingam S. (2014). Plant Expression Platform for the Production of Recombinant Pharmaceutical Proteins. Austin J. Biotechnol. Bioeng. 1(4).
94
Shanmugaraj B. Bulaon CJ I. Phoolcharoen W. (2020). Plant Molecular Farming: A Viable Platform for Recombinant Biopharmaceutical Production. Plants (Basel Switzerland).9, 842. doi: 10.3390/plants9070842
95
Siddiqui A. Wei Z. Boehm M. Ahmad N. (2020). Engineering Microalgae Through Chloroplast Transformation to Produce High-Value Industrial Products. Biotechnol. Appl. Biochem.67. doi: 10.3389/fendo.2013.00006
96
Singh S. Garima S. Kumud T. (2020). Curing of Mammalian Cell Line From Severe Bacterial Contamination. J. Appl. Microb. Res.3, 01–06. doi: 10.3619/2581-7566.1000132
97
Sizova I. A. Lapina T. V. Frolova O. N. Alexandrova N. N. Akopiants K. E. Danilenko V. N. (1996). Stable Nuclear Transformation of Chlamydomonas Reinhardtii With a Streptomyces Rimosus Gene as the Selective Marker. Gene.181, 13–18. doi: 10.1016/s0378-1119(96)00384-8
98
Soria-Guerra R. E. Ramirez-Alonso J. I. Ibañez-Salazar A. Govea-Alonso D. O. Paz-Maldonado L. M. T. Bañuelos-Hernández B. et al . (2014). Expression of an HBcAg-Based Antigen Carrying Angiotensin II in Chlamydomonas Reinhardtii as a Candidate Hypertension Vaccine. Plant Cell Tiss. Organ Cult.116, 133–139. doi: 10.1007/s11240-013-0388-x
99
Specht E. A. Mayfield S. P. (2013). Synthetic Oligonucleotide Libraries Reveal Novel Regulatory Elements in Chlamydomonas Chloroplast mRNA. ACS Synth. Biol.2, 34–46. doi: 10.1021/sb300069k
100
Spolaore P. Joannis-Cassan C. Duran E. Isambert A. (2006). Commercial Applications of Microalgae. J. Biosci. Bioeng.101, 87–96. doi: 10.1263/jbb.101.87
101
Stacey G. N. (2011). Cell Culture Contamination. Methods Mol. Biol.731, 79–91. doi: 10.1007/978-1-61779-080-5_7
102
Takeda H. (1988). Classification of Chlorella Strains by Means of the Sugar Components of the Cell Wall. Biochem. Syst. Ecol.16, 367–371. doi: 10.1016/0305-1978(88)90027-0
103
Tanwar A. Sharma S. Kumar S. (2018). Targeted Genome Editing in Algae Using CRISPR/Cas9. Ind. J. Plant Phys.23, 653–669. doi: 10.1007/s40502-018-0423-3
104
Tripathi N. K. Shrivastava A. (2019). Recent Developments in Bioprocessing of Recombinant Proteins: Expression Hosts and Process Development. Front. Bioeng. Biotechnol.7. doi: 10.3389/fbioe.2019.00420
105
Vafaee Y. Staniek A. Mancheno-Solano M. Warzecha H. (2014). A Modular Cloning Toolbox for the Generation of Chloroplast Transformation Vectors. PloS One9, e110222. doi: 10.1371/journal.pone.0110222
106
Verma D. Daniell H. (2007). Chloroplast Vector Systems for Biotechnology Applications. Plant Phys.145, 1129–1143. doi: 10.1104/pp.107.106690
107
Verma D. Samson N. P. Koya V. Daniell H. (2008). A Protocol for Expression of Foreign Genes in Chloroplasts. Nature Protocols. 3(4), 739–758. doi: 10.1038/nprot.2007.522
108
Wang X. Brandsma M. Tremblay R. Maxwell D. Jevnikar A. M. Huner N. et al . (2008). A Novel Expression Platform for the Production of Diabetes-Associated Autoantigen Human Glutamic Acid Decarboxylase (Hgad65). BMC Biotechnol.17, 8:87. doi: 10.1186/1472-6750-8-87
109
Wang K. Cui Y. Wang Y. Gao Z. Liu T. Meng C. et al . (2020). Chloroplast Genetic Engineering of a Unicellular Green Alga Haematococcus Pluvialis With Expression of an Antimicrobial Peptide. Mar. Biotechnol. (NY).22, 572–580. doi: 10.1007/s10126-020-09978-z
110
Wang K. Gao Z. Wang Y. Meng C. Li J. Qin S. et al . (2021). The Chloroplasts Genetic Engineering of a Unicellular Green Alga Chlorella Vulgaris With Two Foreing Peptides Co-Expression. Algal Res.54, 102214. doi: 10.1016/j.algal.2021.102214
111
Wani S. H. Sah S. K. Sági L. Solymosi K. (2015). Transplastomic Plants for nnovations in Agriculture. A Review. Agron. Sustain. Dev.35, 1391–1430. doi: 10.1007/s13593-015-0310-5
112
Weber S. Grande P. M. Blank L. M. Klose H. (2022). Insights Into Cell Wall isintegration of Chlorella Vulgaris. PLoS One17, e0262500. doi: 10.1371/journal.pone.0262500
113
Xie J. Chen X. Wu J. Zhang Y. Zhou Y. Zhang L. et al . (2018). ntihypertensive Effects, Molecular Docking Study, and Isothermal Titration alorimetry Assay of Angiotensin I-Converting Enzyme Inhibitory Peptides From hlorella Vulgaris. J. Agric. Food Chem.66, 1359–1368. doi: 10.1021/acs.jafc.7b04294
114
Xie W. H. Zhu C. C. Zhang N. S. Li D. W. Yang W. D. Liu J. S. et al . (2014). Construction of Novel Chloroplast Expression Vector and Development of an Efficient Transformation System for the Diatom Phaeodactylum Tricornutum. Mar. Biotechnol. (NY).16, 538–546. doi: 10.1007/s10126-014-9570-3
115
Yaakob Z. Ali E. Zainal A. Mohamad M. Takriff M. S. (2014). An Overview: Biomolecules From Microalgae for Animal Feed and Aquaculture. J Biol. Res.21, 6. doi: 10.1186/2241-5793-21-6
116
Yang B. Liu J. Jiang Y. Chen F. (2016). Chlorella Species as Host for Genetic ngineering and Expression of Heterologous Proteins: Progress, Challenge and erspective. Biotechonol. J.11, 1244–1261. doi: 10.1002/biot.201500617
117
Yuan G. Xu X. Zhang W. Zhang W. Cui Y. Qin S. et al . (2019). Biolistic ransformation of Haematococcus Pluvialis With Constructs Based on the lanking Sequences of its Endogenous Alpha Tubulin Gene. Front. Microbiol.10:749. doi: 10.3389/fmicb.2019.01749
118
Zhang J. Liu L. Chen F. (2019). Production and Characterization of xopolysaccharides From Chlorella Zofingiensis and Chlorella Vulgaris With nti-Colorectal Cancer Activity. Int. J. Biol. Macromol.134, 976–983. doi: 10.1016/j.ijbiomac.2019.05.117
119
Zhang R. Patena W. Armbruster U. Gang S. S. Blum S. R. Jonikas M. C. et al . (2014). igh-Throughput Genotyping of Green Algal Mutants Reveals Random istribution of Mutagenic Insertion Sites and Endonucleolytic Cleavage of. Plant Cell.26, 1398–1409. doi: 10.1105/tpc.114.124099
120
Zhang B. Shanmugaraj B. Daniell H. (2017). Expression and Functional valuation of Biopharmaceuticals Made in Plant Chloroplasts. Curr. Opin. Chem. iol.38, 17–23. doi: 10.1016/j.cbpa.2017.02.007
Summary
Keywords
electroporation, freshwater green algae, homologous recombination, genetic engineering, biopharmaceuticals
Citation
Bolaños-Martínez OC, Malla A, Rosales-Mendoza S and Vimolmangkang S (2022) Construction and Validation of a Chloroplast Expression Vector for the Production of Recombinant Proteins in Chlorella vulgaris. Front. Mar. Sci. 9:884897. doi: 10.3389/fmars.2022.884897
Received
27 February 2022
Accepted
23 May 2022
Published
24 June 2022
Volume
9 - 2022
Edited by
Weiqi Fu, Zhejiang University, China
Reviewed by
Edoardo Andrea Cutolo, University of Verona, Italy; Jesús Agustín Badillo-Corona, Instituto Politécnico Nacional, Mexico
Updates
Copyright
© 2022 Bolaños-Martínez, Malla, Rosales-Mendoza and Vimolmangkang.
This is an open-access article distributed under the terms of the Creative Commons Attribution License (CC BY). The use, distribution or reproduction in other forums is permitted, provided the original author(s) and the copyright owner(s) are credited and that the original publication in this journal is cited, in accordance with accepted academic practice. No use, distribution or reproduction is permitted which does not comply with these terms.
*Correspondence: Sornkanok Vimolmangkang, sornkanok.v@pharm.chula.ac.th; Sergio Rosales-Mendoza, rosales.s@uaslp.mx
†These authors have contributed equally to this work
This article was submitted to Marine Biotechnology and Bioproducts, a section of the journal Frontiers in Marine Science
Disclaimer
All claims expressed in this article are solely those of the authors and do not necessarily represent those of their affiliated organizations, or those of the publisher, the editors and the reviewers. Any product that may be evaluated in this article or claim that may be made by its manufacturer is not guaranteed or endorsed by the publisher.